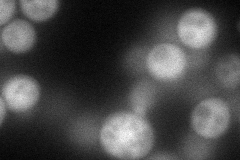
YDR179C
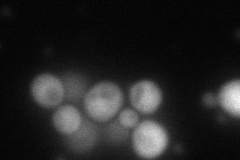
YDR179C
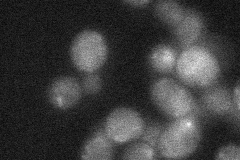
YDR179C
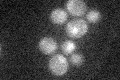
YDR179C

View description
Subunit of the Cop9 signalosome, which is required for deneddylation, or removal of the ubiquitin-like protein Rub1p from Cdc53p (cullin); involved in adaptation to pheromone signaling
Localization:
Intensity:
Fold change:
Significance:
-
C’ GFP library in SD

cytosol20.97 -
N' NOP1pr-GFP in SD
cytosol79.602 -
N' TEF2pr-mCherry in SD
cytosol0 -
N' NATIVEpr-GFP in SD
punctate25.9228 -
N' TEF2pr-VC and Cyto-VN in SD

#N/A0 -
C’ GFP library in SD+DTT

cytosol18.930.9No -
C’ GFP library in SD+H2O2

cytosol18.530.88No -
C’ GFP library in Starvation Media
cytosol19.650.93No -
C’ GFP library on the background of Pup2-DaMP

cytosol -
C’ GFP library on the background of CCT mutant

cytosol20.8980.996326No
